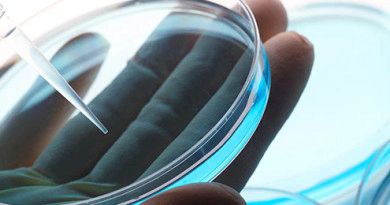

Виділення рожевого кольору замість місячних – причини

У кожної жінки настання місячних, нового циклу менструації, завжди проходить по-різному. У деяких випадках виділення під час місячних можуть бути більш рясніше або менш рясніше, колір і запах кров'янистих виділень під час місячних також може істотно відрізнятися, як і колір виділень під час менструації.
У даній статті будуть детально розглянуті виділення рожевого кольору, які з'являються замість місячних або після менструації.
Що можуть означати рожеві виділення замість місячних, що впливає на колір виділень під час менструації?
Менструація, процес проходження місячних у кожної жінки проходить індивідуально. В одних під час місячних сильно болить живіт, в інших менструація може супроводжуватися появою рясних кров'янистих виділень із піхви, в інших виділення менш рясні або навіть мізерні.
Часто жінки не знають, чи є нормою поява рожевих виділень, коричневих або майже прозорих кров'янистих виділень з піхви. Буде менструація болючою або пройде нормально завжди залежить від багатьох факторів, серед яких такі фактори, як спосіб життя жінки, режим харчування, наявність шкідливих звичок, спадковість і інші численні причини.
Рожеві виділення під час місячних – причини
В деяких випадках жінка може помітити поява рожевих виділень з піхви під час місячних, такі рожеві виділення, які мають рожевий відтінок і насиченість, можуть бути ознаками розвитку багатьох процесів у жіночому організмі. Овуляція може змінювати колір кров'янистих виділень із піхви, з-за цього кров'янисті виділення під час місячних можуть насиченого червоного кольору набувати рожевий відтінок, бути насиченого рожевого, злегка рожевого кольору або майже червоного кольору. Те, який саме колір візьмуть виділення під час місячних, є повністю індивідуальним для кожної жінки, т. к. це залежить відразу від багатьох факторів.
Поява під час місячних кров'янистих виділень рожевого кольору може бути як звичайним, нормальним симптомом звичайного проходження менструації, так і бути ознакою розвитку деяких проблем зі здоров'ям.
Безпечні причини появи рожевих, світло-рожевих виділень під час місячних
Коли з'являються виділення рожевого кольору замість місячних, поява світло-рожевих виділень замість менструації, все те може викликати тривожні відчуття у деяких жінок. У такому випадку потрібно знати, які саме можуть бути причини появи рожевих виділень замість місячних у жінки. Так вагітність жінки може впливати на колір кров'янистих виділень з піхви. Також причиною появи кров'янистих виділень рожевого кольору може стати потрапляння згустку крові в слизову піхви, причому такий згусток може потрапити в піхву до початку менструації або після її завершення.
Настання овуляції в середині циклу місячних (менструації) може вплинути на колір виділень під час місячних. Рожеві кров'янисті виділення під час менструації можуть з'явитися внаслідок змін у щитовидній залозі або внаслідок прийому деяких видів гормональних препаратів. Світло-рожеві виділення під час менструації можуть з'явитися через встановлення невідповідної внутрішньоматкової спіралі (засоби захисту від небажаної вагітності). Виділення рожевого кольору можуть бути і перед початком менструації, до початку місячних.
Помилкова менструація і рожеві виділення з піхви
Помилкова менструація відбувається в той час, коли повинна відбуватися звичайна менструація за календарем, але у жінки за час до цього відбулося запліднення. Так, при вже сталося заплідненні, жінка може відчувати деякі симптоми початку менструації, тягнучі болі в нижній частині живота, коли болить і тягне живіт, з'являються мізерні, не рясні виділення з піхви жінки, частіше всього рожевого кольору. Такі помилкові місячні не несуть ніякої загрози для подальшого розвитку вагітності жінки. Якщо з'являються кров'янисті виділення за тиждень до місячних. то причин появи виділень такого типу може бути ціле безліч.
Рожеві виділення і вагітність
Поява під час вагітності рожевих виділень з піхви може відбуватися під час першого триместру вагітності жінки, в перші місяці виношування плоду. Такі симптоми можуть вказувати на процес закріплення яйцеклітини в стінку матки. Рожеві кров'янисті виділення під час вагітності, в даному випадку, ніяк не впливають на подальший розвиток вагітності жінки. Такі ознаки вагітності лікарі позначають як імплантанційне кровотеча. Слід зазначити, що такі рожеві кров'янисті виділення під час вагітності не можуть бути рясними, а колір їх може бути світло-коричневим, рожевим або світло-рожевим.
Слід пам'ятати про те, що якщо під час вагітності з'явилися рясні кров'янисті виділення з піхви, болі внизу живота або інші хворобливі симптоми, слід одразу ж звертатися за допомогою до лікаря, щоб убезпечити жінку від всіх можливих загроз переривання вагітності.
Овуляція у середині циклу і рожеві виділення
Якщо в середині циклу менструації, місячних у жінки відбувається овуляція, це може призвести до появи незначних кров'янистих виділень замість звичайних симптомів місячних і ознак розвитку менструації.
Гормональна спіраль і рожеві виділення з піхви
Застосування деяких видів гормональних контрацептивів, таких наприклад, як внутрішньоматкова гормональна спіраль, може призвести до появи рожевих виділення під час місячних. Так світло-рожеві або темно-рожеві кров'янисті виділення під час прийому гормональних протизаплідних таблеток або використання гормональної спіралі не вказують на розвиток яких-небудь проблем зі здоров'ям. Звертатися за допомогою до лікаря варто лише в тому разі, коли поява рожевих виділень ставати рясним або переростає в маткова кровотеча.
Коли поява рожевих виділень замість місячних може бути небезпечним?
В деяких випадках, на перший погляд безпричинна поява рожевих виділень під час місячних, світло-рожевих виділень замість менструації, може говорити і про розвиток серйозних гінекологічних захворювань. Слід уважно стежити за своїм самопочуттям, якщо відбуваються збої, незвичайні місячні. Кров'янисті рожеві виділення можуть бути симптомами розвитку запального процесу внутрішніх статевих органів, але в такому випадку з'являються й інші хворобливі симптоми, такі як біль у животі, підвищення температури тіла, озноб і інші ознаки запального процесу.

Іноді поява інфекційного захворювання, розвиток доброякісної пухлини, поява інфекції, все це може привести до появи симптомів у вигляді світло-коричневих або рожевих кров'янистих виділень з піхви замість менструації. Найнебезпечнішою причиною появи такого роду симптомів вважається злоякісна пухлина, тобто ракове захворювання.
Причини рожевих виділень після місячних
Вважається, що поява світло-рожевих виділень після місячних можна вважати нормою і не надавати таких симптомів особливої уваги, але тільки в тому випадку, коли такі рожеві кров'янисті виділення практично прозорі і містять невеликі рожеві домішки, не мають різкого або неприємного запаху, не викликають болю внизу живота або іншого дискомфорту.
Рожеві виділення після місячних (менструації) можуть з'явитися після грубого статевого акту, в результаті якого з'являються мікротріщини в піхву, в результаті використання в якості засобу контрацепції гормональних протизаплідних таблеток, гормональні ОК (оральних контрацептивів). Якщо у жінки спостерігається процес непоновлення менструального циклу, після завершення вагітності, то поява рожевих виділень з піхви після місячних не є патологією або симптомом захворювання, але тільки у випадку відсутності яких-небудь хворобливих симптомів. Внутрішньоматкова спіраль, овуляція, гінекологічні маніпуляції, все це може стати симптомом появи рожевих виділень з піхви після завершення місячних.
Поява рожевих виділень після місячних може бути і наслідком розвитку певних гінекологічних захворювань, таких як ерозія шийки матки, освіта поліпа (поліпів) шийки матки, розвитку хронічного ендометриту або ендоцервіціта, попадання інфекції і розвитку запалення у внутрішніх статевих органах або бути наслідком недостатньої активності щитовидної залози. Корисну інформацію по даній тему можна знайти в статті: причини нездорових виділень з піхви. які виділення з піхви можна вважати нормою, а які вказують на розвиток проблем зі здоров'ям.
Від чого залежить поява болі під час місячних, рясних або необильних кров'янистих виділень?
Вам може сподобатися